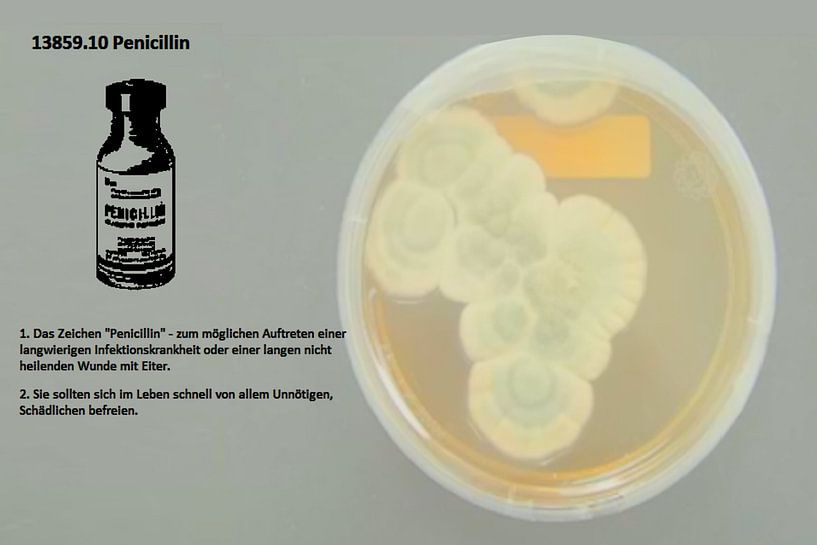
Pénicilline 13859.10 par Vladimir Zykunov

Acheter ce art numérique Pénicilline 13859.10 par Vladimir Zykunov sur toile, aluminium, ArtFrame ou photographie (encadrée), impression d'art en haute définition et tout type de format.
A propos de "Pénicilline 13859.10"
par Vladimir Zykunov
À propos de l'œuvre d'art
Description de la signification du symbole "pénicilline" ;

A propos de Vladimir Zykunov
Lire tous les évaluations
Cette œuvre d'art n'a pas encore de commentaires 4'312 clients nous donnent une note de 4.8 / 5
 Allemagne
Allemagne Commandé en avril 2020
Commandé en avril 2020
 Pays-Bas
Pays-Bas Commandé en août 2017
Commandé en août 2017
 Allemagne
Allemagne Commandé en avril 2019
Commandé en avril 2019
 Allemagne
Allemagne Commandé en octobre 2021
Commandé en octobre 2021
 Allemagne
Allemagne Commandé en janvier 2020
Commandé en janvier 2020
 Pays-Bas
Pays-Bas Commandé en octobre 2019
Commandé en octobre 2019
 Pays-Bas
Pays-Bas Commandé en avril 2021
Commandé en avril 2021
 Allemagne
Allemagne Commandé en mars 2023
Commandé en mars 2023
 Pays-Bas
Pays-Bas Commandé en février 2022
Commandé en février 2022
 Pays-Bas
Pays-Bas Commandé en mai 2024
Commandé en mai 2024
 Pays-Bas
Pays-Bas Commandé en février 2020
Commandé en février 2020
 Allemagne
Allemagne Commandé en novembre 2021
Commandé en novembre 2021
À propos du matériel
ArtFrame™
Des œuvres d'art modifiables sur des toiles modernes
- Impression de haute qualité
- Facilement interchangeable
- Fonction acoustique
- Grands formats disponibles
Découvrir les oeuvres de Vladimir Zykunov
 Adam 17325.10Vladimir Zykunov
Adam 17325.10Vladimir Zykunov Adénoïdes, amygdales 17327.10Vladimir Zykunov
Adénoïdes, amygdales 17327.10Vladimir Zykunov Abcès 11921.10Vladimir Zykunov
Abcès 11921.10Vladimir Zykunov Laxatifs 11709.10Vladimir Zykunov
Laxatifs 11709.10Vladimir Zykunov Dent cassée 17047.10Vladimir Zykunov
Dent cassée 17047.10Vladimir Zykunov Appendicite 17036.10Vladimir Zykunov
Appendicite 17036.10Vladimir Zykunov Ascarides 17378.10Vladimir Zykunov
Ascarides 17378.10Vladimir Zykunov Tache cornéenne 17439.10Vladimir Zykunov
Tache cornéenne 17439.10Vladimir Zykunov Matériel de pansement 16613.10Vladimir Zykunov
Matériel de pansement 16613.10Vladimir Zykunov Vaccins 13068.10Vladimir Zykunov
Vaccins 13068.10Vladimir Zykunov Validol 17524.10Vladimir Zykunov
Validol 17524.10Vladimir Zykunov Ouate médicale 16641.10Vladimir Zykunov
Ouate médicale 16641.10Vladimir Zykunov Médecin 13108.10Vladimir Zykunov
Médecin 13108.10Vladimir Zykunov Poux du pubis 17581.10Vladimir Zykunov
Poux du pubis 17581.10Vladimir Zykunov Plâtre, matériau 17626.10Vladimir Zykunov
Plâtre, matériau 17626.10Vladimir Zykunov Plâtre, bandage 17627.10Vladimir Zykunov
Plâtre, bandage 17627.10Vladimir Zykunov Helminthes 13143.10Vladimir Zykunov
Helminthes 13143.10Vladimir Zykunov Nisse 13147.10Vladimir Zykunov
Nisse 13147.10Vladimir Zykunov Nissen 16689.10Vladimir Zykunov
Nissen 16689.10Vladimir Zykunov Pansement à la moutarde 14440.10Vladimir Zykunov
Pansement à la moutarde 14440.10Vladimir Zykunov

Art digital
Art digital
















